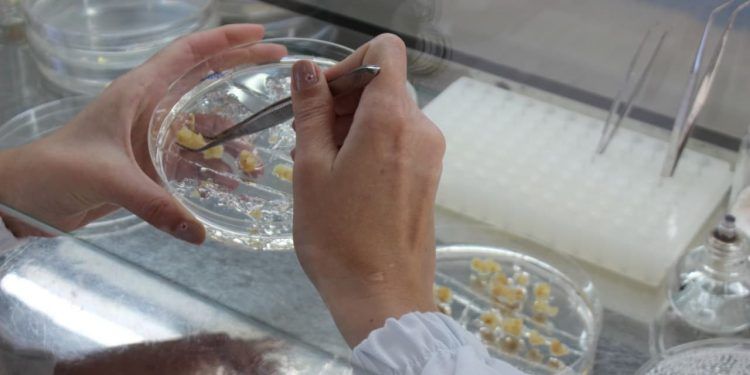

Um estudo conduzido por pesquisadores da Unidade Mista de Pesquisa em Genômica Aplicada a Mudanças Climáticas traça um panorama inédito sobre tecnologias voltadas à inserção precisa de genes no genoma de plantas, com foco especial no milho.
A revisão, desenvolvida em parceria com o Centro de Biologia Molecular e Engenharia Genética (CBMEG) e a Embrapa Agricultura Digital, mostra como novas estratégias de engenharia genética podem tornar esse processo mais eficiente e previsível. O trabalho foi publicado na revista Frontiers in Plant Science.
Tecnologias voltadas à inserção precisa de genes no genoma de plantas

Sediado na Universidade Estadual de Campinas (Unicamp), o GCCRC é um centro de pesquisa aplicada apoiado pela Fundação de Amparo à Pesquisa do Estado de São Paulo (Fapesp) e pela Embrapa.
O grupo atua no desenvolvimento de soluções genéticas e biotecnológicas para ampliar a tolerância das culturas agrícolas a estresses ambientais, reunindo áreas como genômica, microbiologia, melhoramento genético e bioinformática.
Uma das linhas de pesquisa do centro envolve o desenvolvimento de plantas de milho transgênicas ou editadas com maior tolerância à seca. No entanto, a inserção de genes de interesse ainda depende, em grande parte, de métodos aleatórios, nos quais o transgene pode se integrar a regiões instáveis ou inadequadas do genoma. Esse fator torna o processo tradicional mais lento, caro e sujeito a falhas.
Além disso, normas de biossegurança exigem que, para fins comerciais, o transgene esteja presente em cópia única, íntegra e em uma região segura do genoma, condição difícil de garantir quando a integração ocorre ao acaso.
Eventos transgênicos

Segundo Marcos Basso, biotecnologista do GCCRC e autor do estudo, mais de 90% dos eventos transgênicos gerados por integração aleatória resultam em inserções indesejadas, com expressão instável.
Para superar essas limitações, o estudo analisa métodos de inserção sítio-específica e destaca o conceito de “portos seguros genômicos”. Essas regiões do genoma são consideradas estáveis e permitem que os genes inseridos apresentem expressão previsível e sejam transmitidos de forma consistente às gerações seguintes.
De acordo com a pesquisadora Juliana Yassitepe, da Embrapa Agricultura Digital e coautora do trabalho, a utilização desses locais seguros aumenta a eficiência do processo.